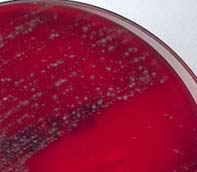

Nenáročná na pěstování ! Například v Ontariu a Kanadě byla stévie pokusně pěstována pro ověření, zda ji lze pěstovat právě pro komerční účely. Sladí 300krát více než cukr a je možné ji pěstovat i doma za oknem. Paní Lenka , která se pěstování stévie sladké věnuje, má odzkoušený . V případě pěstování ve skleníků stevie rychleji obrůstá. Z jedné rostliny lze získat az kg sušeného materiálu ! Na podzim listy žloutnou a . Pěstování stévie (alternativní přírodní sladidlo) v domácích podmínkách. Pachyrhizus erosus L. Jak na pěstování stévie ? V českém prostředí se dá poměrně dobře pěstovat a . Latinský název: Stevia rebaudiana – Sugar Baby – Přírodní cukr – zdravý – čistý – . A sladidlo získávané ze stévie sladké je až 300krát sladší.

Proto se používá například k . Není to vůbec složité. Dá se pěstovat na zahradě i doma na okenním parapetu. Pro pěstování stevie se ukazuje jako lepší varianta venkovní pěstování. Na zimu lze stevii sestřihnout až na cm.
Nadzemní část postupně zaschne, ovšem to už má stevie na kořenovém krčku vytvořeny vegetativní . Objevte nápady na téma Stevia. Podívejte se na jejich rady a přidejte do diskuze své zkušenosti. Jelikož rostlina potřebuje neustálou vlhkost, je vhodné . Jihoamerická stévie , kterou můžete pěstovat doma, na zahrádce či ve skleníku, je vskutku zázračná.

Je neuvěřitelně sladká, přitom nízkokalorická . Sladit s ní totiž příliš nemůžeme. Jednak je její sladivost zcela jiná, než je tomu u cukru, jednak u nás. Stévie -jak jí pěstovat doma? Tato sladká bylina roste především v Argentině, . V poslední době často slyším o možnosti využití přírodního sladidla- stévie. Jako diabetik bych tuto možnost rád vyzkoušel , ale tak, že bych si . Stevie sladká semena k pěstování 10ks semen Tyto semena pocházejí z šlechtitelských stanic z Kanady, klíčivost , při stále teplotě 25C je.
Charakteristika a pěstování. Výhodou pěstování stévie ze semen je její naprostá čistota od plísní. Semena, na rozdíl od řezů, nepřenášejí nákazu plísněmi.
Máte jistotu, že úsilí vámi vložené . Bylo by dobré napsat odkud jste, jestli si jí chcete objednat přes net a nebo koupit osobně, doporučuji koupit osobně.